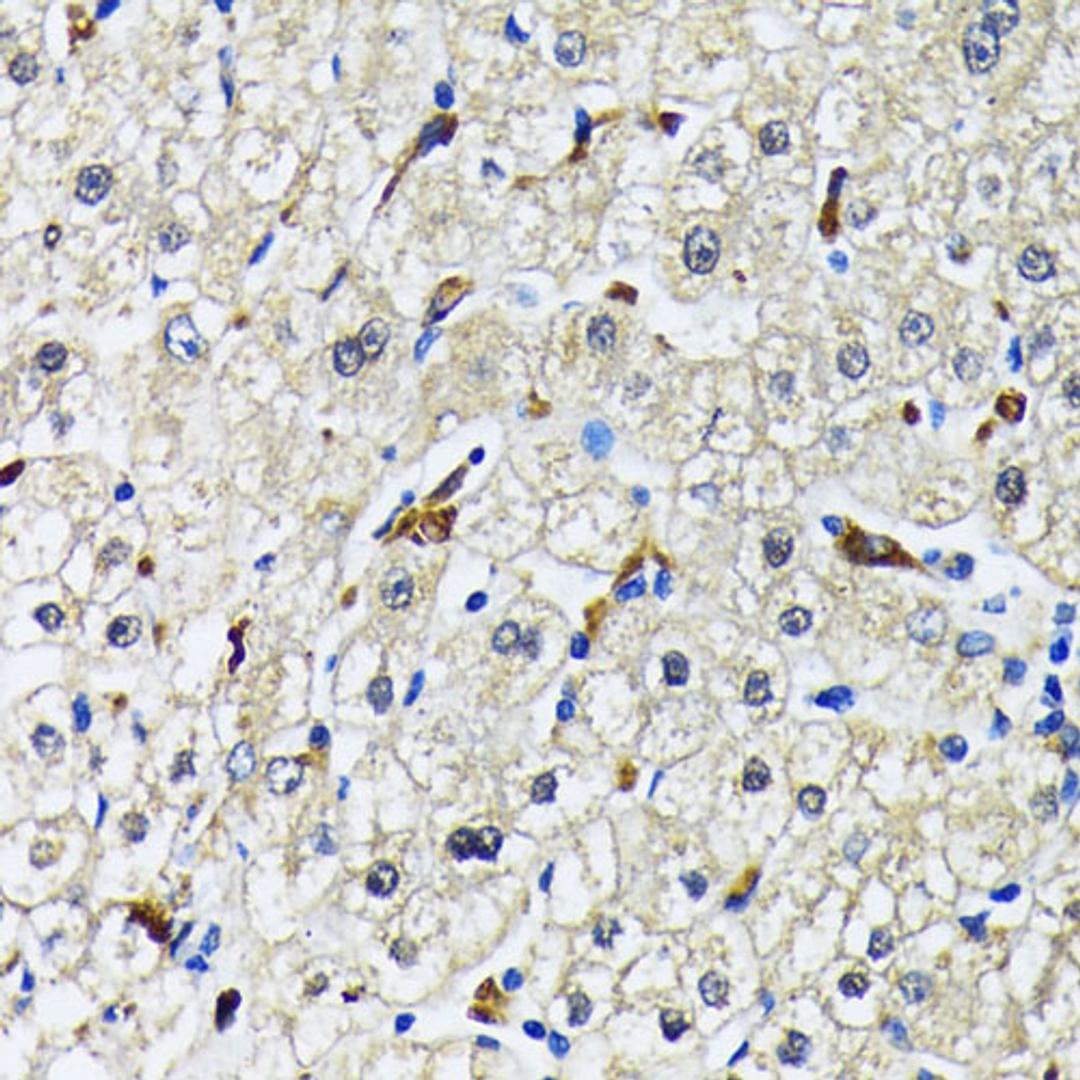
Immunohistochemistry - CD68 antibody (A15037)

CD68 Rabbit pAb
Product Details
- Cat. No.
- A15037
- Type
- Primary Antibody
- Clonality
- Polyclonal
- Host
- Rabbit

The supplier does not provide quotations for this antibody through SelectScience. You can search for similar antibodies in our Antibody Directory.
Description
This gene encodes a 110-kD transmembrane glycoprotein that is highly expressed by human monocytes and tissue macrophages. It is a member of the lysosomal/endosomal-associated membrane glycoprotein (LAMP) family. The protein primarily localizes to lysosomes and endosomes with a smaller fraction circulating to the cell surface. It is a type I integral membrane protein with a heavily glycosylated extracellular domain and binds to tissue- and organ-specific lectins or selectins. The protein is also a member of the scavenger receptor family. Scavenger receptors typically function to clear cellular debris, promote phagocytosis, and mediate the recruitment and activation of macrophages. Alternative splicing results in multiple transcripts encoding different isoforms.
Biological Information
- Clonality: Polyclonal
- Host: Rabbit
- Reactivity: Human, Mouse